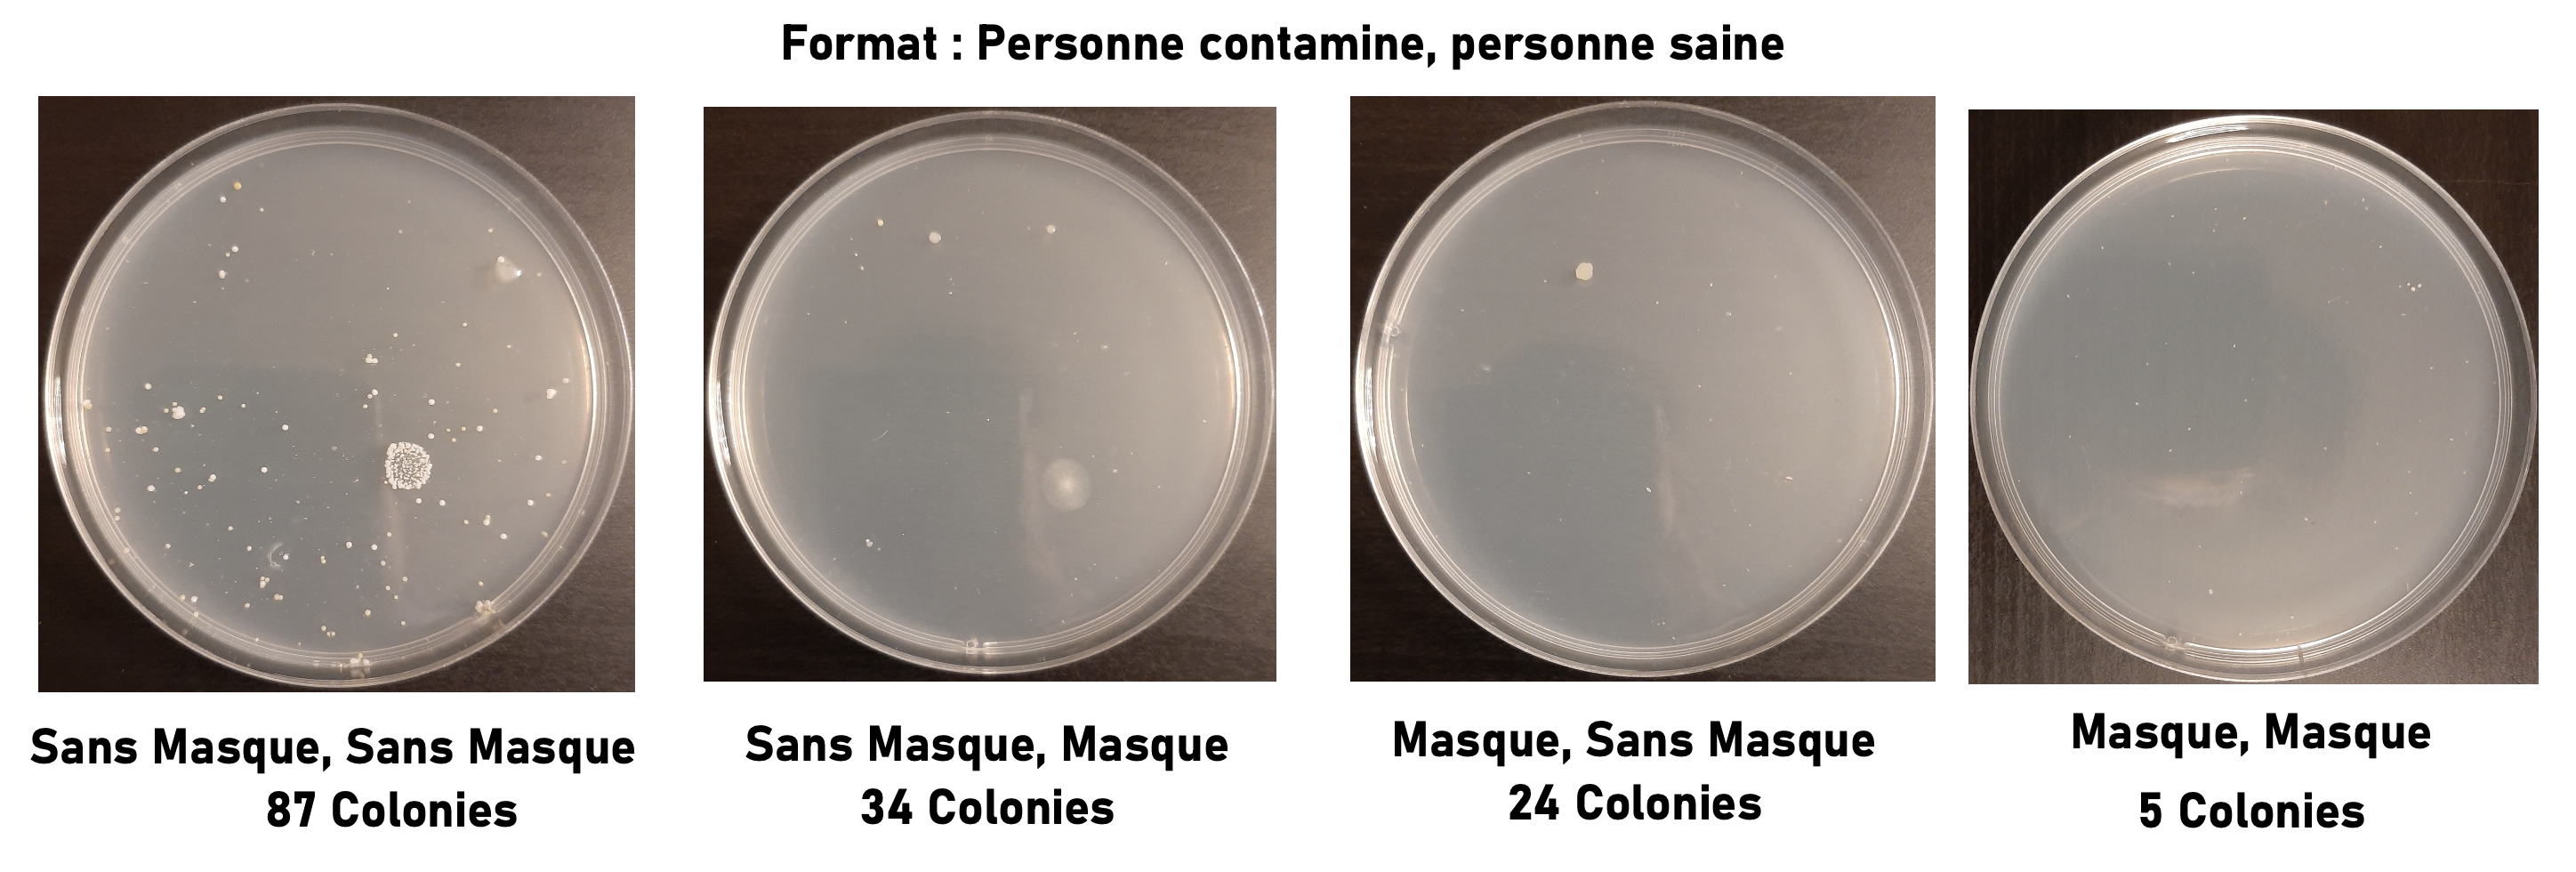
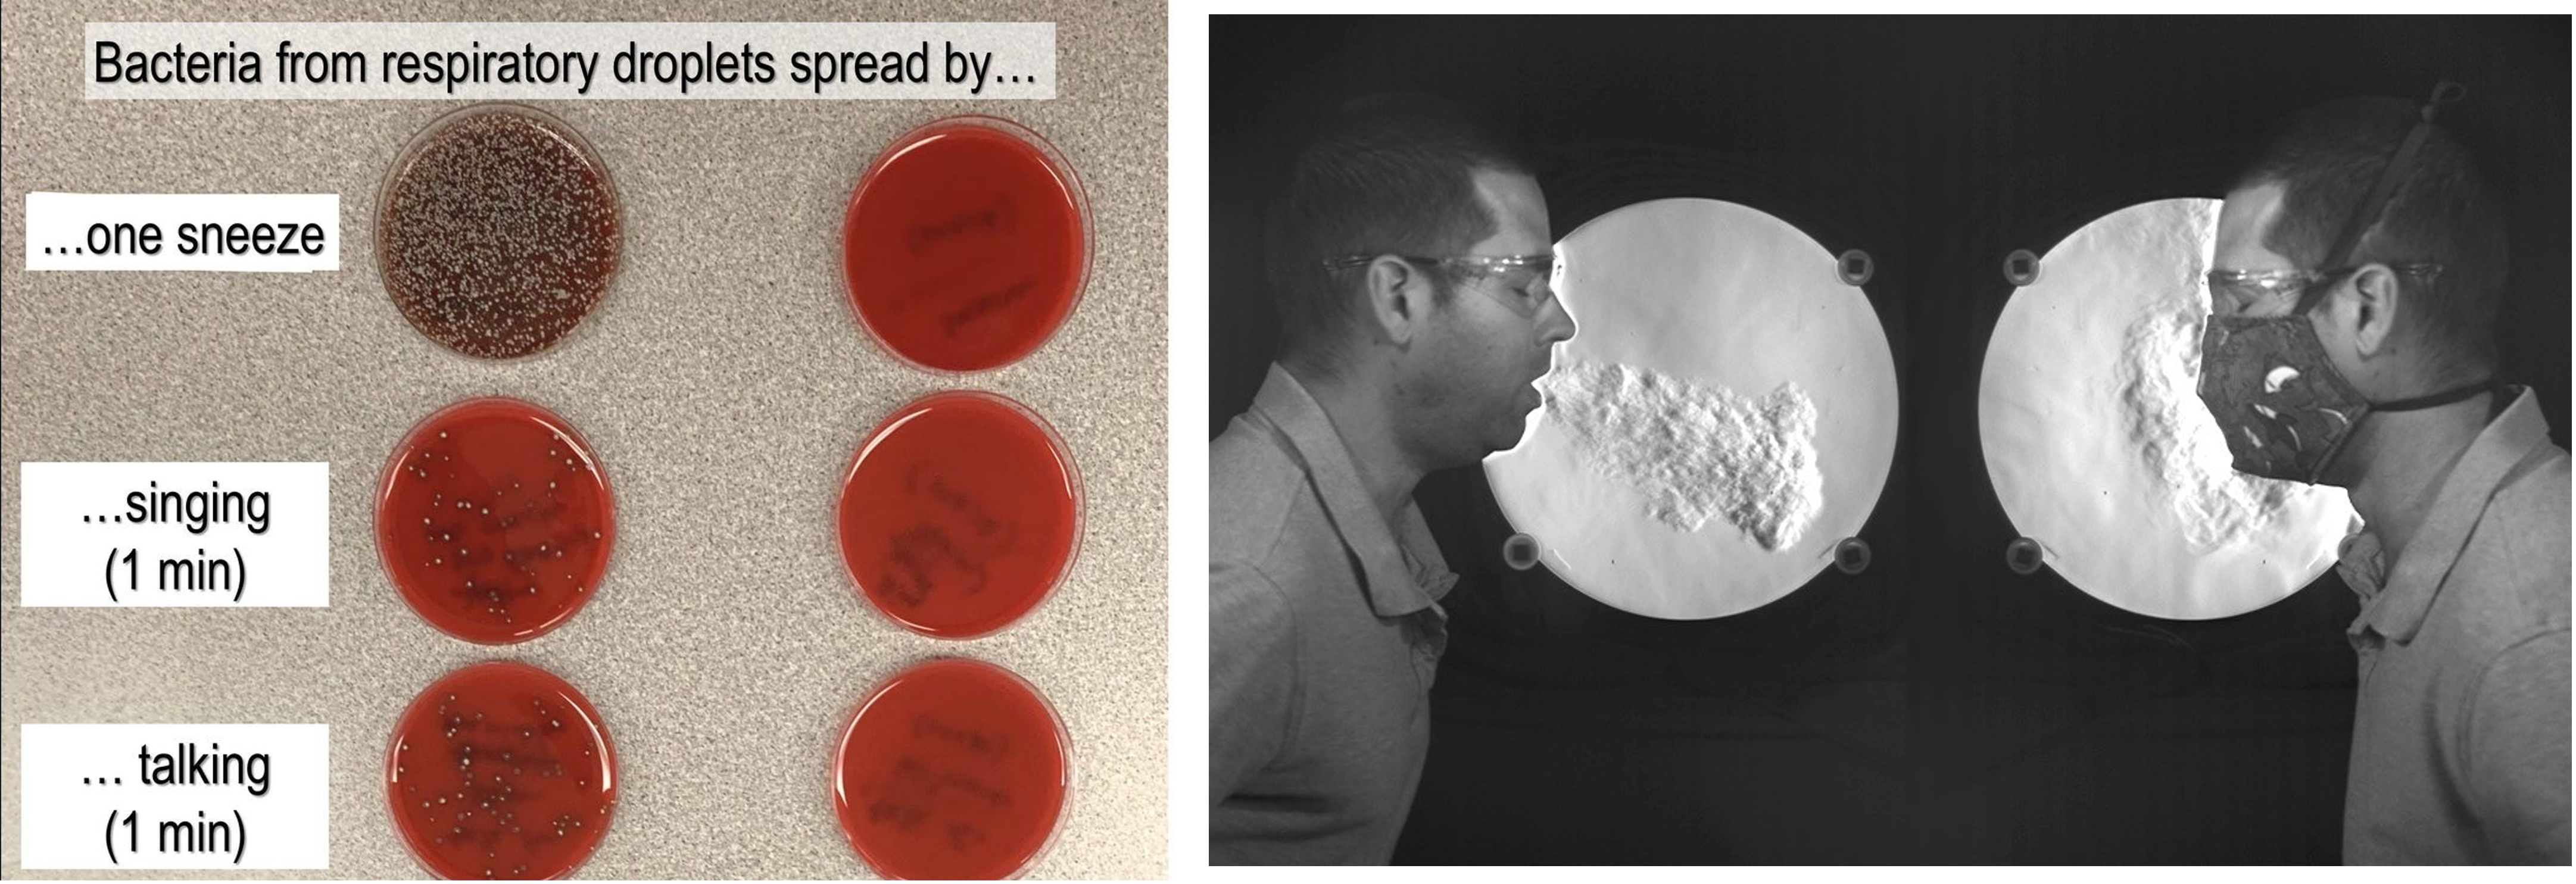

Un grand merci a Mr. Bourdouz pour me donnant des suggestions comment meilleur expliquer mon suject. Un grand merci a Peter Cheung pour me donnant des conseils pour comment utiliser les plats petris.
Objectif
Le port des masques remonte aux médecins de la peste noire du 17e siècle qui portait des cagoules spéciales à long bec, à cause des idées fausses de la transmission des virus. Depuis, dans la pandémie Covid-19, le masque a été la défense la plus utilisée contre le virus. Mon objectif dans cette expérience est d'étudier l'efficacité des différents types de masques (2eme expérience), le masque à usage unique, un masque fait maison (tissu, matériaux synthétique) le masque chirurgical, et le masque KN-95 et les comparer au fait de ne pas porter un masque. Pars ailleurs, je voudrais profiter de mon expérience et aussi savoir qui devrait porter le masque pour être protégé (1ere expérience): est-ce la personne contaminée ou la personne saine?

L'hypothèse
Mon hypothèse pour cette expérience est que le masque KN-95 serait le plus efficace à empêcher la propagation des bactéries. Je pense ceci parce que plusieurs scientifiques ont montré la grande efficacité de filtrage du masque N-95 contre tous les variants du virus (dépasse les 95%, contre un masque chirurgical ~40%).
Les Variables
Les Variables Indépendantes:
- Le montant de salive après chaque toux
- Distance parcourue par la salive
- Le nombre de bactéries en fonction de l'humidité de l'air
Les Variables Dépendantes:
- Le nombre de colonies dans le plat pétri
Les Variables Contrôlées:
- La distance entre le plat pétri et la bouche de la personne qui tousse
- Le type de masque utilisé dans l'expérience ou la combinaison de masques utilisés pour la première expérience
Matériels
- Des plats pétris avec du agar nutritif
- Différents masques : un masque fait maison (tissu, matériaux synthétique), masque chirurgical, masque à usage unique, et un masque KN-95
- Une règle de plus de 60 cm
- Une table de plus de 60 cm
- Un ordinateur avec :
- Excel
- Python + Plotly + JupyterNotebook
- CountThings By Camera
Procédure
Pour chaque type de masque (2ème expérience, C'est quoi le masque le plus efficace?) ou pour chaque combinaison de masques (1ère expérience, Qui devrait porter le masque?) :
- Je place les plats pétris aux distances suivantes : 20cm, 40cm, et 60cm pour la 2ème expérience, ou seulement la distance de 20cm pour la première expérience.
- Je tousse sur tous les plats pétris en portant le masque spécifié.
- Je mets les plats pétris dans un endroit chaud (~35˚C) et non-humide, répliquant l'environnement d'un incubateur, l'environnement idéal pour la croissance des colonies de bactéries. Ensuite, j'attends pour que les colonies puissent grandir (environ 4 jours, après le temps sans résultats mais avant que la moisissure ne commence à se développer).
- Après avoir attendu les 4 jours, je compte le nombre de colonies en utilisant l'application « CountThings By Camera ».
La Collecte de Données
Résultats de la Première Expérience
| Expérience [Contaminée, Saine] | Distance (cm) | Nombre de Colonies |
|---|---|---|
| Sans Masque, Sans Masque | 20 | 87 |
| Sans Masque, Avec Masque | 20 | 34 |
| Avec Masque, Sans Masque | 20 | 24 |
| Avec Masque, Avec Masque | 20 | 5 |
Résultats de la Deuxième Expérience
| Expérience | Distance (cm) | Nombre de Colonies | Type de Masque |
|---|---|---|---|
| Sans masque | 20 | 113 | Sans masque |
| Sans masque | 40 | 102 | Sans masque |
| Sans masque | 60 | 81 | Sans masque |
| Masque chirurgical | 20 | 57 | Masque chirurgical |
| Masque chirurgical | 40 | 43 | Masque chirurgical |
| Masque chirurgical | 60 | 35 | Masque chirurgical |
| N95 | 20 | 31 | N95 |
| N95 | 40 | 28 | N95 |
| N95 | 60 | 26 | N95 |
| Tissu synthétique | 20 | 71 | Tissu synthétique |
| Tissu synthétique | 40 | 61 | Tissu synthétique |
| Tissu synthétique | 60 | 55 | Tissu synthétique |

Résultats de la Première Expérience
La Représentation
La Foire des Sciences | Mark Danishevsky
La protection des différentes combinaisons de masques entre la personne contaminée et la personne saine [Graphique à barres] (Première expérience)
La protection des différentes combinaisons de masques entre la personne contaminée et la personne saine [Graphique en entonnoir] (Première expérience)
La protection des différentes types de masques [Graphique en entonnoir] (Deuxième expérience)
La protection des différentes types de masques [Graphique en nuage de points] (Deuxième expérience)
Analyse et Conclusion
Dans ma deuxième expérience (C'est quoi le masque le plus efficace?), j'ai trouve que le masque le plus efficace a arrêter la propagation de bactéries était le masque N-95, validant mon hypothèse. La deuxième masque la plus efficace est le masque chirurgical, suivi par le masque fait maison, suivi finalement par ne pas porter un masque. Cela signifie que c'est plus sécuritaire de porter un bon masque comme le N-95, que de ce distancer 60cm avec un masque non- efficace comme le masque fait maison, ou même le masque chirurgical. Mes donnes montrent aussi que n'importe quel masque que tu porte, c'est beaucoup plus efficace que de ne pas porter un masque. Mes donnes sont aussi conformes de l'étude « Evaluation of Cloth Masks and Modified Procedure Masks as Personal Protective Equipment for the Public During the COVID-19 Pandemic » par Philip W. Clapp et 7 autres scientifiques, qui ont trouvées que l'efficacité de la filtration du masque N-95 est beaucoup plus grande que l'efficacité de la filtration du masque chirurgical.
Résume
Dans mes expériences j'ai trouvé :
- Le masque a un effet protecteur en respect à la transmission de bactéries.
- Dans une situation où il y a un masque qui doit être sur la personne saine ou sur la personne contaminée, il est plus sécuritaire qu'il soit porté par la personne contaminée.
- Le masque le plus efficace est le N-95, suivi par le masque chirurgical, le masque fait maison, et finalement ne pas porter de masque.
- Plus grande est la distance entre la personne contaminée et la personne saine, moins la personne saine reçoit de bactéries.
Recherches Faites
“Effectiveness of Face Masks in Preventing Airborne Transmission of SARS-CoV-2”
par Hiroshi Ueki et 6 autres scientifiques de l'université de Tokyo. Publié le 21 octobre 2020 par NCBI.
Observations :
- Porter un masque a un effet protecteur en respect à la transmission de gouttelettes infectieuses de COVID-19.
- L'efficacité d'un masque devient plus élevée lorsque le propagateur porte un masque plutôt que la victime.
- Les masques N-95, même complètement scellés, n'ont pas complètement bloqué la propagation de COVID-19.

« Evaluation of Cloth Masks and Modified Procedure Masks as Personal Protective Equipment for the Public During the COVID-19 Pandemic »
par Philip W. Clapp et 7 autres scientifiques. Publié le 10 décembre 2020 par JAMA Network.
Observations :
- L'efficacité de la filtration des masques de consommateurs varie de 26.5% à 79.0%.
- Des modifications prévues pour améliorer l'efficacité peuvent augmenter la filtration d'un masque commercial de 38.5% à 80.5%.

« Filtration Efficiency of Hospital Face Mask Alternatives Available for Use During the COVID-19 Pandemic »
par Emily E. Sickbert-Bennett et 2 autres scientifiques. Publié le 11 août 2020 par JAMA Network.
Observations :
- L'efficacité des masques N-95, lorsqu'ils ne sont pas portés dans la bonne taille, peut diminuer de ~95% à ~90%.
- Les masques N-95 expirés et des alternatives ajustées ont la même efficacité de filtration après stérilisation.

Autres recherches
Liens:
- Lien vers NCBI
- Lien vers JAMA Network (1)
- Lien vers JAMA Network (2)
- Lien vers YouTube
- Lien vers NIST Blog
- Lien vers Twitter

